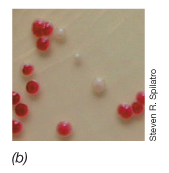

What are mutations? How do they occur?
What are some different kinds of mutations?

What is a frameshift mutation?
1) What is a mutant?
2) What is wild-type strain?
3) What is a parent strain?
4) Give an example
1) A bacterial strain carrying a mutation in a specific gene (a change in the sequence of the gene compared to the sequence in the wild-type or parent strain.
2) a natural bacterial isolate that carries no known mutations. Often though, a strain can be said to be “wild-type” for a certain gene or phenotype while having mutations in other genes. So, an E. Coli strain can be wild-type for lactose utilization (i.e. Lac+) while having mutations in the genes for ribose catabolism (Rib-).
3) The strain that was used to give rise (spontaneously or experimentally) to a mutant. The parent strain, or just parent, may or may not be a wild-type strain or wild-type for the gene in question.
4) Rough colony: Loss or change in lipopolysaccharide layer. Granular, irregular colonies instead of smooth, glistening colonies.
1) What are reversions
2) What is same site?
3) What is second site?
1) A mutation that restores a mutant to the wild-type phenotype, but often NOT by changing the sequence back to exactly as before.
2) Can be a “true revertant” in which case the sequence is restored to that of the starting strain (parent or wild-type).
3) Reversion occurs somewhere else on the DNA, “suppresses” (i.e., compensates for) the mutation (example: a mutation in the lac operator that allows a mutated LacI protein to bind normally).
Mutations rates for errors in DNA replication?
1) What is selection and screening used for?
2) What is the process?
1) Used to find a strain carrying a specific mutant.
2) Selecting for a strain of E. Coli that is resistant to streptomycin.
- Thus antibiotic is bacteriocidal (kills, compare to bacteriostatic, stops reproduction while present), and normally E. Coli is sensitive to it.
- Streptomyocin binds to the 30S subunit of the ribosome, causing a misreading of mRNA.
- Spontaneous mutation occurs at low frequency in the sequence of the 16s rRNA gene such that the 16s RNA made is slightly different in sequence, and the antibiotic cannot bind.

1) Does the antibiotic cause the mutation?
2) What does the antibiotic selective?
1) The antibiotic does not cause the mutation.
2) The antibiotic selects for the mutants that have naturally arisen (at very low frequency) during normal DNA replication.
- The antibiotic allows the mutant to grow, but it kills the wild-type
- If the kind of mutation is not selectable, it still might be possible to screen for it, just by looking for colonies that look different. Ex: screening for UV radiation-induced pigment-less mutants of Serratia marcescens.
1) In what other ways can we screen for a specific mutant?
2) What is an auxotroph?
3) What is a prototroph?
4) Provide an example of this screening test.
1) We can look for colonies that do not grow. Ex: screening a bacterial culture for a specific kind of nutritional auxotroph.
2) a bacterial strain that by mutation has a nutritional requirement.
3) the parent strain from which an auxotrophic mutant has arisen.
4) A methionine auxotroph.
- Most E. coli strains are prototrophic for methionine, meaning that they can synthesize methionine from simple precursors (i.e., glucose, ammonia). An E. coli methionine auxotroph is a strain that can no longer carry out one or more of the enzymatic steps for synthesis of methionine; it cannot make methionine, so it can grow only if it gets methionine from the environment (i.e., from the culture medium). That loss of ability is due to a mutation in one or more of the genes that code for the enzymes of methionine biosynthesis.

What are the three mechanisms of DNA transfer in bacteria? Give the name and a description.

What maintains the genetic integrity of the bacterial chromosome?
1) How do bacterial cells digest incoming DNA?
2) Why is it important for a cell to be able to digest this incoming DNA?
3) How does a bacterium protect its own DNA from its own restriction endonuclease?
1) Digestion of incoming DNA by restriction endonuclease of recipient cell. Enzyme recognizes a specific DNA sequence (recognition sequence, an inverted repeat/palindrome) and cuts there or nearby.
2) Important to maintain the integrity of its genome and DNA is a good source of C, N, and P for bacterial nutrition.
3) By “modification”. A specific modification enzyme modifies a bacterial strain’s own DNA, often via methylation (addition of a methyl group, -CH3) at certain nucleotides within the restriction enzyme recognition sequence - by this modification, the bacterium labels its own DNA as “self”; the restriction endonuclease no longer recognizes that sequence and so it does not cut.

1) What is a palindromic site?
2) There are two different end products that restriction cuts leave, what are they?
1) Reads the same on the reverse DNA strand as it does on the forward strand.
2) EcoR1 (E. coli) - leaves “sticky” end (overhang). Sma1 (Serratia marcescens) - leaves a blunt end.
1) What is the process of non-reciprocal homologous recombination?

Explain the selection for recombination experiment (hint: Trp)
1) Did transformation occur?
2) How can transformation be detected?
